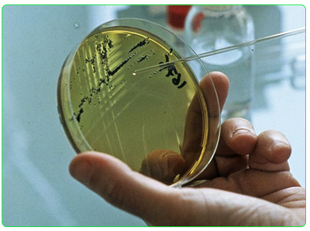
Biologie Veterinaire

Qu'est ce que La Biologie Véterinaire ?
SCIENTILABO pratique la biologie vétérinaire et unit son expertise en biologie à ses savoir-faire reconnus en biologie humaine tels que la logistique, et son exemplarité en qualité. Notre engagement est axé autour du maintien d’une biologie de proximité avec accès à une technologie de pointe au service des vétérinaires.
Pourquoi Nous Choisir?
SCIENTILABO a pour vocation d’accompagner tous les vétérinaires praticiens en leur proposant une solution complète de diagnostic in vitro. Nous sommes avant tout une équipe multidisciplinaire de biologistes et de technicien à votre écoute pour vous orienter, vous informer, vous aider dans votre démarche diagnostique.